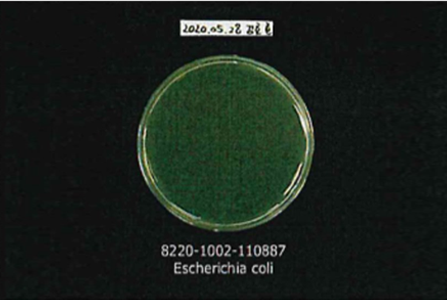

시트/필름
일반하드코팅EP-100 Series
Double/Single Side Hard Coating
PMMA, PC, PET 등 투명시트 표면에 하드코팅 되어있으며, 우수한 투명도와 내구성을 부여한 제품입니다.



김서림방지EP-200 Series
Anti-Fog
PMMA, PC, PET 등 투명시트 표면에 코팅 되어 있으며 기온이나 습도차이로 생기는 김서림 현상을 방지 합니다.



눈부심방지(무광)EP-300 Series
Anti-Glare
PMMA, PC, PET 등 투명시트 표면에 코팅 되어 있으며 기온이나 습도차이로 생기는 김서림 현상을 방지 합니다.



대전방지EP-400 Series
Anti-Static
PMMA, PC, PET, PVC, ABS 등 투명시트 표면에 대전방지 코팅이 되어있으며, 패널의 표면 저항을 줄여 주어 정전기가 생기는 것을 예방해 줍니다.
장비 커버 및 반도체 라인 커버 등 다양한 용도로 활용 가능합니다.



지문방지EP-600 Series
Anti-Static
PMMA,PC 2~3 LAYER, PET등 투명시트 표면에 Anti-Finger Coating 되어있으며, 수접촉각 110˚에 가까운
제품으로 뛰어난 오염방지 특성과 함께 표면을 쉽게 닦을 수 있고, 지문이 남는 것을 방지합니다.



Glastic 백커버용 복합시트EP-SF00U
2Layer Bare Sheet
스킨층은 PMMA, 코어층은 PC로 구성되어 외관 및 품질이 우수하며, 인쇄 및 포밍이 용이합니다.

Glastic 백커버(2.5D)용 고 내마찰성 코팅EP-50LFU
2Layer Super Anti-Scratch Coating
PMMA, PC 2~3LAYER, PET 등 투명시트 표면에 Anti-Finger Coating 되어있으며, 수접촉각 110˚에 가까운 제품으로 뛰어난 오염방지 특성과 함께 표면을 쉽게 닦을 수 있고, 지문이 남는 것을 방지합니다.


향균 필름
Anti-Virus Film
Clear Type의 Hard Coating 제품, 잦은 터치로 인한 마모에 대비하여 내구성을 향상시켰고 향균 기능이 극대화된 제품입니다.

컬러비산방지 필름
Color Anti-Scattering Film
일반 비산방지(투명) 필름 및 PET필름에 컬러 하드코딩을 통한 컬러 구현 가능
유리에 부착되어 깨짐 발생시 파편 튐을 방지하는기능과 금속표면에 컬러 또는 패턴 효과를 부여한 제품입니다.



Sheet/Film 물성 Data
| 일반하드코팅 | 김서림방지 | 눈부심방지(무광) | 대전방지 | 지문방지 | 고 내마찰성 | |
|---|---|---|---|---|---|---|
| 경도 | PMMA : 4H PC : HB |
PMMA : 3H PC : HB |
PMMA : 4H PC : HB |
PMMA : 3H PC : HB |
PMMA : 4H PC : HB |
PMMA : 4H PC : HB |
| 투과율 | PMMA : 91% PC : 90% |
90% 이상 | 80~90% 이상 | 90% 이상 | 90% 이상 | 90% 이상 |
| HAZE | 0.5 미만 | 1 미만 | 5~30% 조절가능 | 0.5 미만 | 0.5 미만 | 0.5 미만 |
| DDP인쇄 | 우수 | X | X | X | X | X |
| 방무효과 | X | 우수 | X | X | X | X |
| 표면 저항력 | X | X | X | 10^6 ~10^8 | X | X |
| 수접촉각 | X | X | X | X | 105 이상 | 105 이상 |
| 내약품성 | X | X | X | X | 우수 | 우수 |
| 내마찰성 | X | X | X | X | 우수 | 우수 스틸울 1,000회 이상 |
